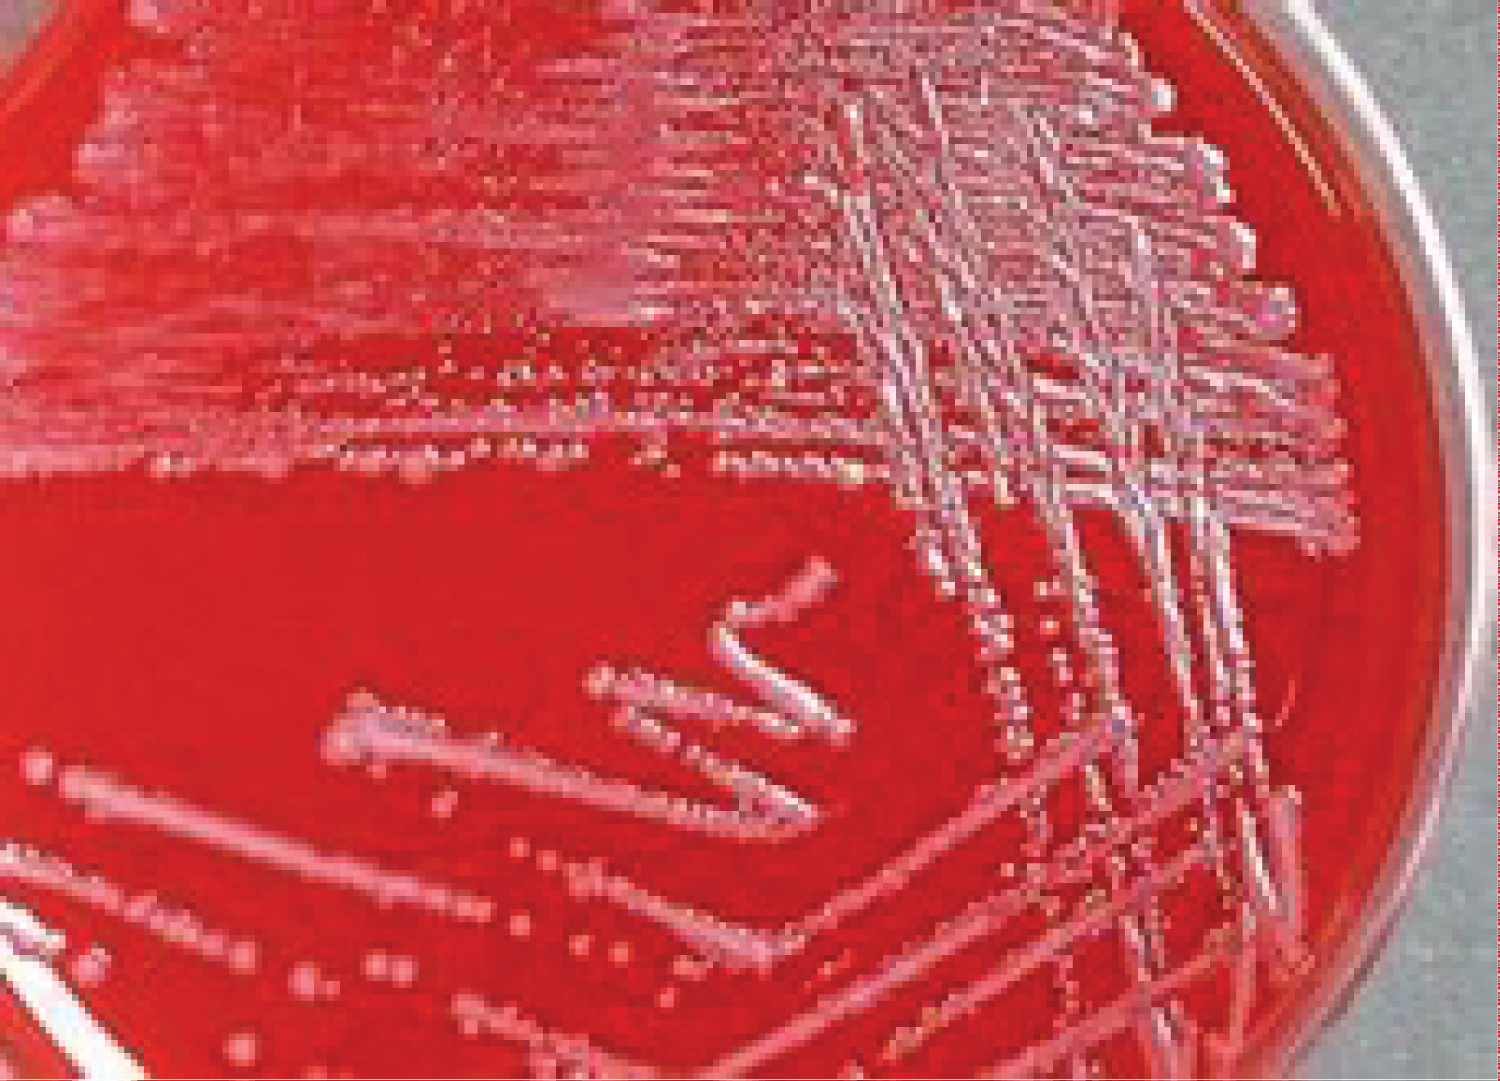

A 10-year-old female with Down syndrome was admitted with a 5-day history of fever, rigors, and progressive dyspnea. Admitting assessment revealed the presence of a right-sided Bacteroides fragilis pneumonia and empyema. Shortly after admission, the child’s respiratory condition deteriorated when she drained an unsuspected right lung abscess into the opposing lung. She was placed on assisted ventilation and intravenous clindamycin with gradual improvement in her clinical condition. Because patients with Down syndrome have oropharyngeal anatomical abnormalities and low esophageal muscle tone, they are prone to develop aspiration pneumonias involving oropharyngeal flora, including B. fragilis. Their immunity is also impaired due to T and B cell lymphopenia, defective neutrophil chemotaxis, impaired antibody responses to immunizations, and diminished T cell proliferation in response to mitogens, making the management of infectious diseases more challenging than one would expect in an immunocompetent patient. Proper positioning of patients with large lung abscesses to prevent aspiration of its contents into the opposing lung is an important aspect of patient care.
Down syndrome, Aspiration, Pneumonia, T cell immunity, B cell immunity, Bacteroides fragilis
The patient is a 10-year-old girl who had been admitted to a State Institution for the Mentally Impaired at the age of five. She was in good health until 5 days prior to admission when she developed fever and progressive dyspnea. She was empirically placed on intravenous gentamicin at a dose of 8 mg/kg given every 24 hours. She failed to improve and was transferred to the Pediatric Ward of our hospital.
Physical examination revealed an acutely ill child with a respiratory rate of 20 breaths per minute, a blood pressure of 105/70 mmHg, a pulse rate of 110 beats/minute, and a rectal temperature of 38.5 degrees centigrade. Her breath was fetid. Flatness to percussion, decreased tactile fremitus, diminished breath sounds, and distant inspiratory crackles were noted over the right posterior chest. The physical examination was otherwise unremarkable except for findings typical of Down syndrome (brachycephaly, epicanthic folds, Brushfield spots, upslanting palpebral fissures, and a single palmar crease).
The patient’s admitting chest X-ray showed a large right-sided pleural effusion and an infiltrate involving the right lower lobe (Figure 1). Gram stains of her sputum and pleural fluid revealed numerous neutrophils and slender Gram-negative rods. She was placed on intravenous clindamycin at a dose of 30 mg/kg/24 hours. Shortly after admission her condition suddenly worsened when, while lying on her left side, she aspirated the contents of a large and unsuspected right lung abscess into her left lower lobe (Figure 2). Her condition gradually improved with intensive respiratory therapy including tracheal suctioning and continuous positive airway pressure oxygen administration.
 Figure 1: Admitting chest X-ray shows a large right pleural effusion and a pneumonic infiltrate in the right lower lobe.
View Figure 1
Figure 1: Admitting chest X-ray shows a large right pleural effusion and a pneumonic infiltrate in the right lower lobe.
View Figure 1
 Figure 2: An X-ray taken shortly after admission shows a new infiltrate in the left lower lobe. An unsuspected right lung abscess had aspirated into the left lung.
View Figure 2
Figure 2: An X-ray taken shortly after admission shows a new infiltrate in the left lower lobe. An unsuspected right lung abscess had aspirated into the left lung.
View Figure 2
Anaerobic cultures of the empyema, sputum, and tracheobronchial secretions grew Bacteroides fragilis (Figure 3). The organism was sensitive to clindamycin and resistant to aminoglycosides.
Figure 3: Anaerobic cultures of the sputum and pleural fluid grew Bacteroides fragilis.
View Figure 3
Figure 3: Anaerobic cultures of the sputum and pleural fluid grew Bacteroides fragilis.
View Figure 3
Aspiration pneumonias are unusually common in persons with Down syndrome [1-3]. A number of factors account for this predilection, including anatomical abnormalities of the upper airway (macroglossia and narrow nasopharynx) [4,5], dysphagia due to pharyngeal and esophageal hypotonia [6,7], and gastroesophageal reflux due to gastric hypotonia [8,9]. Impairment of cognition may also lead to difficulties in recognizing and responding to choking hazards, further increasing their risk of aspiration [10]. Proper positioning and early intervention programs focusing on feeding and swallowing techniques can help mitigate this risk [10]. And speech-language therapy aimed at improving oral motor skills and swallowing function can also be beneficial in reducing the incidence of aspiration in patients with Down syndrome [11,12].
Aspiration pneumonias typically involve one or more of the oropharyngeal flora where anaerobes (bacteroides, peptostreptococci, and fusobacterium) usually outnumber aerobic bacteria [13-15]. Persons who aspirate in the supine position are likely to involve the right lower lobe (as in the presented case) whereas those that aspirate in the upright or sitting position are likely to involve the right middle lobe. The presented case developed an anaerobic lung and pleural infection with Bacteroides fragilis . This organism is predictably resistant to aminoglycosides, explaining the lack of response of the child to gentamicin. And, apropos to the presented case, B. fragilis is a common isolation in patients with cavitating pneumonia and empyema [16].
Proper positioning of patients with large lung abscesses is necessary to prevent aspiration of the abscesses’ contents into the opposing lung such as occurred in the presented case. Once positioned, the abscess can be drained by bronchoscopy using a device such as a pigtail catheter [17].
Persons with Down syndrome are also at increased risk of viral and aerobic bacterial pneumonias as compared to the general population [1]. Chromosome 21, which is triplicated in Down syndrome, harbors a number of immune-related genes including those that code for interferon receptors (IFRs), ubiquitin associated and SH3 domain containing A (UBASH3A), and autoimmune regulator (AR). As a result Down syndrome patients have reduced chemotaxis, altered toll-like receptor signaling, impaired immunoglobulin G and complement responses, reduced responses to vaccines, and accelerated immune system aging [18-20].
The author is grateful for the support of the Department of Education.
The author claims there is no conflict of interest.